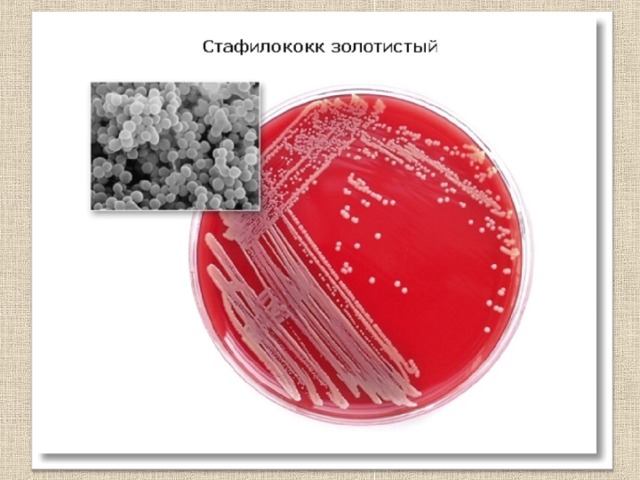
Спектр действия антибиотиков

Лекарства
Каширина Т. Ю. учитель биологии МБОУ «СОШ № 19» г. Набережные Челны

Содержание
- Историческая справка
- Получение лекарственных препаратов из растений
- Современные лекарственные препараты
- Антибиотики
- Противомикробное действие антибиотиков
- Спектр действия антибиотиков
- Противомикробные средства
- Анестезирующие средства Гормоны как лекарства
- Сосудосуживающие средства
- Анальгетические средства
- Наркотические анальгетики
- Лекарственные формы

Историческая справка
- Лекарства известны человеку с глубокой древности
- В одном из египетских папирусов ( XVII в. до н.э.) описываются лекарственные средства растительного происхождения
- Некоторые из них, например, касторовое масло используются и в наши дни

Гиппократ
- Великий древнегреческий врач Гиппократ (460 – 377 г до н. э.) искал причины болезней в окружающей среде, климате, образе жизни и питания
- Призывал лечить не болезнь, а больного
- Описал более двухсот лекарственных растений и способов их употребления

Клавдий Гален
- Клавдий Гален, римский врач (129 – 201) заложил основу фармакологии
- Применял вытяжки из растений, настаивал их на воде, уксусе, вине
- Спиртовые вытяжки – экстракты и настойки находят широкое применение и в современной медицине

Авиценна
В сочинениях Абу Али Ибн Сины – Авиценны, великого среднеазиатского врача (980 – 1037) описано большое количество лекарственных препаратов растительного и минерального происхождения и способов их приготовления

Парацельс
- Теофраст Парацельс, швейцарский естествоиспытатель (1493 – 1541) начал использовать для лечения болезней минеральные воды и химические препараты: соединения сурьмы, мышьяка, меди, свинца, ртути и других элементов
- Заложил основы медицинской химии
- Актуально до сих пор его утверждение об огромной важности количества применяемого препарата:
- «Все есть яд, ничего не лишено ядовитости, и все есть лекарство. Лишь только доза делает вещество ядом или лекарством»

Получение лекарственных препаратов из растений

В начале XIX в. были открыты первые алкалоиды – биологически активные азотсодержащие органические соединения растительного происхождения
1803г. – открыты алкалоиды опия
Чуть позже из листьев чайного дерева был выделен кофеин, обладающий стимулирующим действием

1820 г. – из коры хинного дерева выделен хинин - эффективное средство для борьбы с малярией
Из листьев дерева кока получен кокаин, проявляющий анестезирующие свойства

Из корня красавки был получен атропин, купирующий приступ бронхиальной астмы

Современные лекарственные препараты

Антибиотики
Антибиотики – вещества, обладающие противомикробным действием
К ним относят продукты нормальной жизнедеятельности различных микроорганизмов – плесеней, бактерий, актиномицетов, а также растений и животных
Антибиотики, выделяемые некоторыми высшими растениями (черной смородиной, луком, чесноком, редькой, горчицей, черемухой и др.), называют фитонцидами
В настоящее время известны более тысячи антибиотиков, многие из которых синтезированы

Наиболее активным в группе антибиотиков является бензилпенициллин ( открыт А. Флемингом, 1928 г)
Натриевая и калиевая соли пенициллина до сих пор эффективно используют для борьбы с возбудителями опасных заболеваний – газовой гангрены, столбняка, пневмонии, менингита, гонореи, сифилиса, дифтерии и сибирской язвы, септических инфекций
В настоящее время широко применяются полусинтетические пенициллины – оксациллин и ампициллин

В 1960 г. появились представители новой группы антибиотиков - цефалоспорины
7-аминоцефалоспориновая кислота


Широкое применение в лечении инфекционных болезней находят и другие антибиотики: тетрациклины, полимиксины, препараты групп эритромицина, левомицетина, стрептомицина, неомицина

Противомикробное действие антибиотиков
Бактерицидное
Бактериостатическое
Вызывают уничтожение микроорганизмов
Задерживают рост и размножение микроорганизмов
Пенициллины
Цефаллоспорины
Полимиксины
Неомицин
Стрептомицин
Нистатин
амфотерицин
Тетрациклин
Левомицетин
Эритромицин
олеандомицин

Спектр действия антибиотиков

Спектр действия антибиотиков

Помните, что…
Антибиотики – мощное оружие,
но, попадая в организм, они уничтожают не только
патогенные, но и полезные микроорганизмы, например, микрофлору кишечника
Активно помогая организму бороться с болезнью, антибиотики позволяют ему «расслабиться», постепенно снижая уровень
иммунитета, ослабляя собственные защитные реакции
Нельзя заниматься самолечением антибиотиками
Противомикробные средства
Дезинфицирующие – обеззараживание окружающей среды
Антисептические – обеззараживание кожи, слизистых, ожогов, ран
- Известь хлорная, хлорамин Б
- Фенол
- Этанол, раствор формальдегида
- Раствор аммиака
- Сулема HgCl 2
Химиотерапевтические – избирательное воздействие на микроорганизмы в органах и тканях, менее токсичны для организма
- «Галогены» – раствор иода спиртовой, раствор Люголя, иодоформ
- Ароматические соединения – ихтиол, бальзам Вишневского
- Алифатические соединения – этанол, раствор формальдегида
- Красители – метиленовый синий, бриллиантовый зеленый
- Окислители – перекись водорода, перманганат калия
- Производные нитрофурана – фурациллин
- Кислоты и щелочи – кислота борная, раствор аммиака
- Соли тяжелых металлов - AgNO 3 , протаргол ZnSO 4
- Синтетические противобактериальные средства : сульфаниламидные препараты (стрептоцид, сульфадимезин, этазол, уросульфан, сульфазин, сульфадиметоксин, фталазол), энтеросептол и его аналоги
- Противотуберкулезные средства: стрептомицин, ПАСК (натриевая сольпарааминосалициловой кислоты)
- Противомалярийные средства (хинин, акрихин, хиноцид, хингамин)
- Противоамебные средства (метронидазол)
- Противотрихомонадные средства (метронидазол – трихопол, фуразолидон)
- Противовирусные средства (амантадин, ремантадин, оксолин, интерферон)

Анестезирующие средства
Анестезирующие средства – вещества, временно блокируют нервные окончания – рецепторы и поэтому применяются для местной анестезии – обезболивания
К ним относятся: новокаин, дикаин, лидокаин
Лидокаин широко применяется для всех видов анестезии, так как хорошо всасывается через слизистые оболочки

В качестве лекарств могут использоваться и гормоны:
Адреналин – в отличии от норадреналина вызывает сужение лишь периферийных сосудов – кожи и слизистых оболочек (человек бледнеет), но расширяет сосуды сердца и мышц, усиливает и учащает сердечные сокращения (пульс)
Норадреналин – вызывает резкое сужение сосудов, повышение кровяного давления

Сосудосуживающие средства
Эфедрин – стимулирует дыхательный и сосудодвигательный центры, расслабляет мускулатуру бронхов, снимает приступы астмы, облегчает аллергические реакции
Нафтизин, галазолин – сужают сосуды слизистой оболочки носа, уменьшают отечность и воспалительные реакции при рините (насморке)

Анальгетические средства
Снять боль можно не только блокируя нервные окончания – болевые рецепторы или передачу нервных импульсов в мозг
Некоторые лекарственные препараты устраняют болевые ощущения, воздействуя непосредственно на ЦНС
Они называются анальгетическими средствами или анальгетиками

Анальгетики
- Делятся на 2 группы
- К первой из них относятся: салициловая кислота и ее производные (аспирин), производные пиразолона (амидопирин, анальгин) и производные анилина (парацетамол)
- Эти анальгетики ослабляют или снимают чувство боли, не оказывая влияния на работу ЦНС – их называют ненаркотическими анальгетиками

Наркотические анальгетики
Наркотические анальгетики, в отличие от первых, не только ослабляют или снимают чувство боли, но вызывают эйфорию – отсутствие неприятных ощущений и переживаний, боли, недомогания, страха, тревоги, голода и жажды и состояние наркоза – утрату чувствительности и потерю сознания
Вызывая состояние наркоза, они создают уникальные условия для хирургических операций, снимают болевые шоки, облегчают страдания безнадежных больных

К слабодействующим наркотическим анальгетикам относится и этиловый спирт
Наркотик вызывает формирование лекарственной зависимости – болезненного пристрастия к препарату, делающего невозможным существование человека без приема все больших доз наркотика
Прекращение употребления наркотика или снижение дозы вызывает абстинентный синдром – болевой шок, сопровождающийся тяжелыми психическими нарушениями и патологическими явлениями со стороны органов и тканей

Лекарственные формы

Лекарственные формы
Жидкие
Твердые
- Растворы (водные, в том числе для инъекций, спиртовые, глицериновые, масляные)
- Настои
- Отвары
- Настойки
- Экстракты
- Микстуры
- Слизи
- Эмульсии
- Суспензии
Мягкие
- Порошки
- Гранулы
- Таблетки
- Драже
- Пилюли
- Капсулы
- Смеси нарезанного или крупно измельченного растительного сырья (иногда с примесью солей, эфирных масел)
- Мази
- Линименты (жидкие мази)
- Пасты
- Суппозитории (свечи)
- Стерильные порошки и таблетки для инъекций, растворяемые непосредственно перед введением


Факторы, влияющие на лечебный эффект лекарственных средств
Доза – терапевтический диапазон индивидуален для каждого лечебного средства
Режим приема и способы применения – определяются длительностью действия и циркуляции, накопления и выведения лекарства из организма
Взаимное влияние назначаемых препаратов
Состояние организма
Лекарственные формы


 Получите свидетельство
Получите свидетельство Вход
Вход

Лекарства (44.75 MB)
Лекарства (44.75 MB)
 0
0 1349
1349 31
31 Нравится
0
Нравится
0


